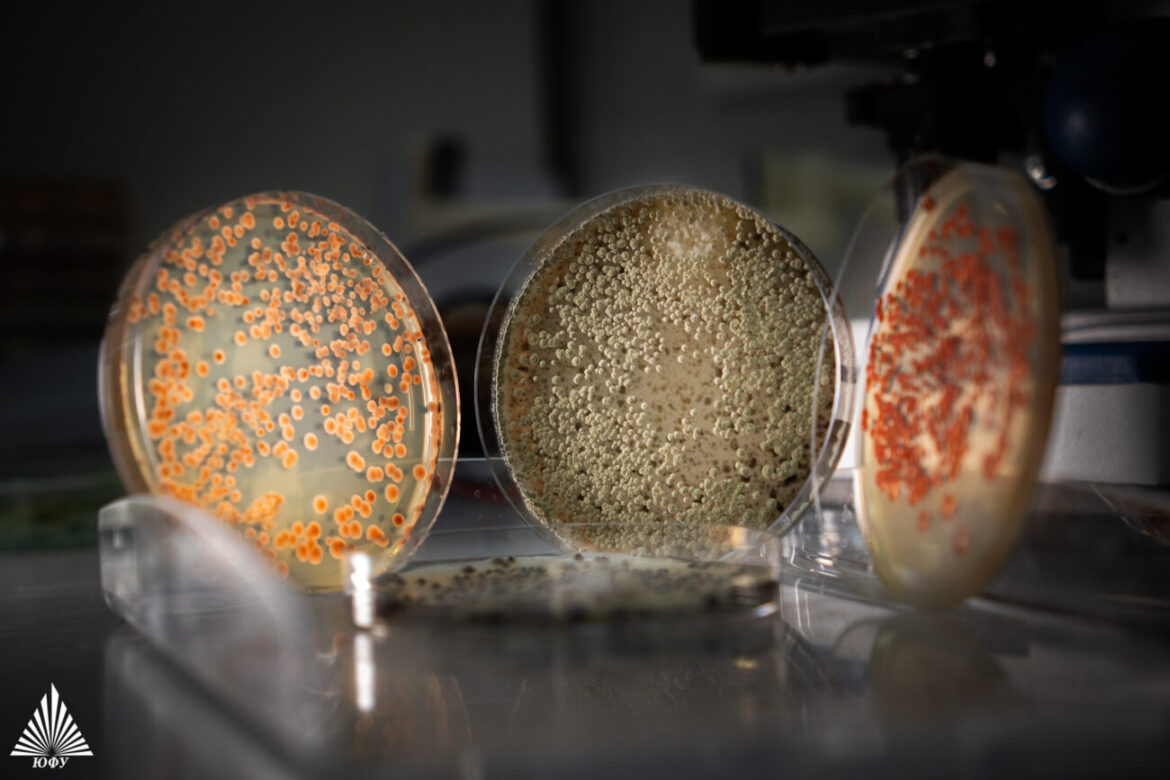

Ученые Академии биологии и медицины Д. И. Ивановского ЮФУ в рамках совместного проекта с Институтом медико-биологических проблем (ИМБП) РАН провели уникальный космический эксперимент. Разработанный ими консорциум из десяти штаммов микроорганизмов был запущен на орбиту на борту научного космического аппарата «Бион-М» № 2 и успешно вернулся на Землю после приземления 18 октября. Уже в ноябре почва, доставленная с Марса, дала первую жизнь — в ней проросли всходы ячменя.

Цель эксперимента — изучить, как сложное сообщество бактерий и грибов переносит экстремальные условия космического полета: повышенную радиацию, невесомость и перегрузки. Уровень радиационного воздействия на орбите высотой 370-380 км более чем в 200 раз превышал земной фон и был на 30% выше, чем на Международной космической станции. Теперь биологам предстоит оценить выживаемость микроорганизмов и проанализировать, как космический полет повлиял на частоту мутаций в их ДНК.
Что такое микробный консорциум и зачем он нужен?
Микробный консорциум — это специально подобранное сообщество микроорганизмов (бактерий, дрожжей), которые совместно культивируются и помогают друг другу расти и выживать, вступая в сложные симбиотические взаимосвязи. Отправленный в космос образец обладает повышенной устойчивостью к экстремальным условиям, включая излучения и засуху.
В его состав вошли новые штаммы почвенных бактерий и грибов, отобранные из природных и техногенно загрязненных почв Ростовской области. Каждый участник этого «микробного коллектива» выполняет свою функцию: цианобактерии в составе сообщества отвечают за фотосинтез, актиномицеты и бациллы — за наработку биомассы. Некоторые из них продуцируют вещества, способные увеличить плодородие почв, другие – обеспечивают устойчивость к окислительному стрессу.
От восстановления земных почв до садов на Марсе
Основное назначение этого консорциума — биоремедиация, то есть восстановление свойств загрязненных человеком территорий или плодородного слоя почвы после пожаров. Полезные вещества, выделяемые бактериями, позволяют быстрее образоваться гумусу — органическому веществу почвы.
Однако у технологии есть и более амбициозная задача — освоение безжизненных субстратов, таких как почвы пустынь, Крайнего Севера или даже других планет. В лаборатории ЮФУ уже больше двух месяцев параллельно идет эксперимент по культивации этих бактерий в искусственном «марсианском» реголите. Этот грунт, хоть привезен и не с Марса, а из пустыни Мохаве, прекрасно имитирует свойства красного песка, покрывающего поверхность соседней планеты.
«Отправив аналогичный консорциум в полет на орбиту, мы сможем выяснить, как подобная смесь микроорганизмов переживает космические полеты, а значит, еще на шаг приблизиться к смелой мечте о садах на поверхности Марса», — отмечают доктор биологических наук, заведующая молодежной лабораторией «Молекулярная генетика микробных консорциумов» АБиМ ЮФУ Евгения Празднова.
После приземления капсулы с биологическими образцами были доставлены в Москву для проведения детальных исследований. Результаты этой работы позволят не только оценить пределы живучести земных микроорганизмов, но и приблизят человечество к созданию устойчивых замкнутых экосистем для жизни вне Земли.
Месяц спустя ученые подтвердили, что все микроорганизмы в составе консорциума успешно пережили полет, хотя некоторые из них немного замедлили рост, а входившие в состав красные дрожжи Rhodothorula мутировали, показав повышенное число белых непигментированных клеток. Теперь предстоит детально изучить геном «космических» микроорганизмов.
Источник: ЮФУ


